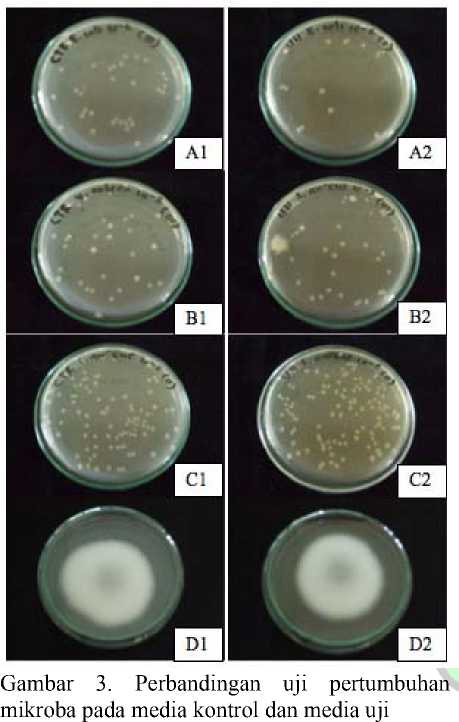

UJI KOMPATIBILITAS KARAGINAN DARI Eucheuma cottonii DAN Eucheuma spinosum DENGAN AGAR KOMERSIAL SEBAGAI PEMADAT (SOLIDIFIER) MEDIA PENUMBUH MIKROBA
on
JURNAL FARMASI UDAYANA
Vol. 5 No 1 Tahun 2016
ISSN2301-7716
UJI KOMPATIBILITAS KARAGINAN DARI Eucheuma cottonii DAN Eucheuma spinosum DENGAN AGAR KOMERSIAL SEBAGAI PEMADAT (SOLIDIFIER) MEDIA PENUMBUH MIKROBA
Laksmiani, N. P. L.1, Suciptha, K.R.1, Widjaja, I N., Ramona, Yan1.
1 Jurusan Farmasi – Fakultas Matematika dan Ilmu Pengetahuan Alam – Universitas Udayana
Korespondensi: Ni Putu Linda Laksmiani
Jurusan Farmasi Fakultas Matematika dan Ilmu Pengetahuan Alam Universitas Udayana Jalan Kampus Unud-Jimbaran, Jimbaran-Bali, Indonesia 80364 Telp/Fax: 0361-703837
Email: lindalaksmiani@gmail.com
ABSTRAK
Penelitian mengenai uji kompatibilitas karaginan diekstrak dari Eucheuma cottonii dan Eucheuma spinosum dengan agar-agar komersial telah dilakukan di Laboratorium Terpadu Biosains dan Bioteknologi, Universitas Udayana. Karaginan dari dua rumput laut diekstraksi dengan alkali berair (pH 8,5) di 80o-85oC selama 4 jam. Beberapa parameter, seperti tes kekakuan, elastisitas dan kemampuan media tumbuh mikroba (E. coli, Staphylococcus aureus, Vibrio Colera Dan Rhizopus sp.) dari karaginan rumput laut diuji dan dibandingkan dengan agar-agar komersial. Data dianalisis secara statistik menggunakan uji T. Hasil penelitian menunjukkan bahwa semua parameter yang diuji untuk karaginan yang diekstrak dari Eucheuma cottonii kompatibel dengan agar komersial (P <0,05), meskipun biaya untuk memproduksi 1 L media adalah dua kali lebih mahal daripada agar komersial. Sementara itu, karaginan yang diekstraksi dari Eucheuma spinosum tidak dapat digunakan sebagai solidifier karena gel yang terbentuk lemah.
Kata kunci: kompatibel, karaginan, Eucheuma cottonii, Eucheuma spinosum, media tumbuh mikroba.
kedua terbesar di Indonesia (Anonim b, 2009).
Di Kecamatan Nusa Penida, rumput laut yang dibudidayakan adalah Eucheuma cottonii dan Eucheuma spinosum. Jenis rumput laut tersebut mengandung karaginan yang memiliki nilai ekonomis. Karaginan adalah suatu hidrokoloid yang diperoleh dengan ekstraksi menggunakan air atau larutan alkali dari kelompok Rhodophyceae (alga merah) (Rowe dkk., 2004). Karaginan merupakan senyawa polisakarida yang dapat membentuk gel dan berfungsi sebagai pengental (viscosifying agent) (V andamme dkk., 2004). Kadar karaginan dalam setiap spesies Eucheuma yang tumbuh di Indonesia berkisar antara 61,5%-67,5%. Selain karaginan, dalam Eucheuma juga terdapat beberapa zat organik lain seperti protein, lemak, serabut kasar, abu, dan air (Aslan, 1998).
Beberapa tahun yang lalu rumput laut
hanya dimanfaatkan sebagai bahan makanan manusia. Seiring kemajuan ilmu pengetahuan dan teknologi, pemanfaatan rumput laut telah meluas di berbagai bidang, seperti bidang pertanian (digunakan oleh beberapa negara sebagai bahan pupuk organik dan pembuatan salah satu media tumbuh dalam kultur jaringan), di bidang peternakan (digunakan sebagai makanan ternak), dan pada bidang mikrobiologi (digunakan sebagai salah satu komponen media untuk kultur bakteri) (Aslan, 1998).
Media kultur bakteri banyak digunakan baik pada bidang pendidikan maupun di bidang kesehatan sehingga diperlukan pengetahuan tentang pembuatan media. Dengan kekayaan laut Indonesia yang begitu melimpah dan banyaknya spesies rumput laut yang tumbuh, maka perlu dipelajari jenis rumput laut yang dapat dipakai untuk komponen pemadat media pertumbuhan bakteri dengan mutu tinggi.
Berdasarkan pada latar belakang tersebut, maka dilakukan penelitian tentang kompatibilitas agar dari rumput laut yang dibudidayakan di Bali (Eucheuma cottonii dan Eucheuma spinosum) untuk menumbuhkan mikroba.
-
2. BAHAN DAN METODE
-
2.1 Bahan Habis Pakai
-
Aquadest, KOH, KH2PO4, Isopropil alkohol, Larutan KCl 10%, Methylen Blue, Nutrien Broth, Nutrien Agar, Potato Dextrosa Agar, Potato Dextrosa Broth, Normal Saline
-
2.2 Materi Hidup
Bahan-bahan hidup yang digunakan yaitu rumput laut jenis Eucheuma cottonii dan Eucheuma spinosum yang dibudidayakan di Kecamatan Nusa Penida. Isolat mikroba yang digunakan dalam penelitian ini adalah E. coli, Staphylococcus aureus, dan Vibrio colera yang diperoleh dari UPT Laboratorium Biosains dan Bioteknologi Universitas Udayana. Sedangkan jamur Rhizopus sp. diperoleh dari Laboratorium Mikrobiologi Fakultas MIPA Universitas Udayana.
-
2.3 Prosedur Penelitian 2.3.1 Ekstraksi karaginan
Ditimbang masing-masing 20 gram rumput laut jenis Eucheuma cottonii dan Eucheuma spinosum yang telah bersih dan kering, direndam dalam air tawar selama 24 jam, kemudian dibilas dan ditiriskan.
Ekstraksi dilakukan secara terpisah pada masing-masing jenis rumput laut dengan perlakuan yang sama. Rumput laut yang telah direndam dimasukkan ke dalam tangki ekstraksi dan ditambahkan dengan 800 ml larutan pengekstrak. Ekstraksi dilakukan selama 4 jam pada temperature 80°-85°C (Bawa dkk., 2007; Syamsuar, 2007). Ekstraksi dengan cara yang sama diulang sebanyak 5 kali.
Hasil ekstraksi disaring dengan filter. Filtrat yang diperoleh diendapkan dengan menambahkan isopropil alkohol sebanyak 1,5 kali volume filtrat karaginan. Setelah mengendap, filtrat disaring untuk memisahkan air yang masih tersisa. Endapan yang diperoleh kemudian diuapkan dengan evaporator pada suhu 80° C dan dikeringkan dengan menggunakan oven pada suhu 60° C sampai bobotnya konstan.^
-
2.3.2 Uji Kekerasan Agar
Penentuan kekerasan agar dilakukan dengan cara melarutkan karaginan hasil ekstraksi dengan air, sehingga diperoleh konsentrasi 1%; 1,5%; 2%; 2,5%; 3%. Campuran dihomogenkan dengan stirrer, dipanaskan sampai mendidih, dituangkan ke dalam cawan petri sebanyak 20 ml. Sebelum diuji, sediaan dikeringkan pada inkubator paling sedikit selama 2 jam dan dibiarkan pada suhu ruang paling sedikit 2 jam untuk mencapai kesetimbangan thermal (Fulthorpe, 1951). Sediaan diuji dengan diberikan tekanan (penambahan beban) sedikit demi sedikit sampai tercapai tekanan yang dapat memecahkan/merusak agar (nilai kekerasan). Selanjutnya dibuat persamaan regresi dengan x = konsentrasi karaginan dan y = nilai kekerasan. Dari persamaan regresi tersebut, nilai kekerasan produk komersial (kontrol) dimasukkan ke dalam persamaan sehingga dapat ditentukan konsentrasi karaginan yang memiliki kekerasan
yang sama dengan media kontrol.^
-
2.3.3 Uji Streak Ose
Sediaan uji (konsentrasi karaginan yang memiliki nilai kekerasan sama dengan agar komersial konsentrasi 1,5%) dan sediaan kontrol disiapkan dan dikondisikan sama seperti uji kekerasan agar. Dibandingkan kerusakan yang terjadi akibat tekanan yang diberikan dengan menggunakan ose.^
-
2.3.4 Uji Kompatibilitas untuk menumbuhkan bakteri
Untuk menilai kompatibilitas media untuk menumbuhkan bakteri, maka dilakukan uji Spread Plate suspensi biakan beberapa bakteri (E. coli, Staphylococcus aureus, dan Vibrio colera) yang telah disiapkan sebelumnya. Sebanyak 0,1 ml suspensi bakteri yang telah diencerkan sampai 10-5, 10-6, dan 10-7 disebar pada permukaan media uji dan media kontrol, dibiarkan mengering, diinkubasi pada 37°C selama 24-48 jam dan dilakukan penghitungan jumlah koloni yang tumbuh. Koloni yang tumbuh pada kedua kelompok media di atas dibandingkan. Uji ini dilakukan sebanyak 3 kali, dan hasilnya dibandingkan secara statistik.^
-
2.3.5 Uji Kompatibilitas untuk menumbuhkan jamur
Media PDA yang dibuat dengan bahan karaginan rumput laut dan yang komersial (kontrol), diuji kompatibilitasnya dengan cara menginokulasikan media tersebut dengan potongan miselia jamur (1x1 cm), diinkubasi pada 37oC selama 24 jam, dan diukur diameter pertumbuhannya dengan jangka sorong (Vernier Caliper). Uji ini dilakukan sebanyak 3 kali agar dapat dibandingkan secara statistik.
-
2.4 Analisa Data
Data yang diperoleh dianalisis dengan Independent T-Test menggunakan Software Minitab for Windows versi 14 yang digunakan untuk membandingkan kompatibilitas agar dari Eucheuma cottonii dan Eucheuma spinosum dengan media yang umumnya ada dipasaran (kontrol) dilihat dari kesamaan pada uji streak ose, kemampuan menumbuhkan bakteri dan
jamur. Hasil penelitian dinyatakan memiliki perbedaan bermakna jika diperoleh nilai (P < 0,05) dan dinyatakan tidak berbeda bermakna jika nilai (P > 0,05) pada taraf kepercayaan 95%.
-
3. HASIL
Rendemen berat kering karaginan hasil ekstraksi Eucheuma cottonii dan Eucheuma spinosum dengan umur panen 30 hari berturut-turut adalah 33,71% dan 32,96%. Hasil ini serupa dengan yang dilaporkan oleh Syamsuar (2007) yang memperoleh rendemen hasil ekstraksi karaginan yang berkisar antara 29,69% - 34,63% (umur panen 40, 45, dan 50 hari). Menurut Aslan (1998) dan Poncomulyo dkk. (2006), lama waktu panen paling baik adalah 1,5-2 bulan, dengan penumbuhan selama waktu tersebut, kandungan karaginan pada Eucheuma sp. telah mencapai kadar tertinggi. Namun pada penelitian kali ini, dengan umur panen 30 hari, rendemen yang diperoleh serupa dengan umur panen 40, 45, dan 50 hari. Hal ini dapat disebabkan karena kadar karaginan juga tergantung pada kondisi lingkungan tempat penumbuhan (Aslan, 1998; Syamsuar 2007) sehingga dapat diperoleh hasil yang serupa pada umur panen 30 hari.^
Identifikasi karaginan pada kedua jenis rumput laut dengan methylene blue, diperoleh hasil adanya endapan serabut berwarna biru (Gambar 1). Hasil ini menunjukkan bahwa sampel positif mengandung karaginan (Anonim, 2007). Berdasarkan identifikasi lanjutan untuk mengetahui jenis karaginan, diperoleh hasil bahwa karaginan yang diekstraksi dari Eucheuma cottonii termasuk karaginan tipe kappa. Hal ini berdasarkan pada sifat gel yang terbentuk yang cenderung bersifat rapuh (brittle). Sedangkan karaginan yang diekstrak dari Eucheuma spinosum termasuk karaginan tipe iota karena gel yang terbentuk sangat elastis. Perbedaan sifat gel yang terbentuk karena penambahan garam kalium (KCl) pada saat pengujian. Kappa karaginan sensitif terhadap ion kalium dan membentuk gel kuat dengan adanya garam kalium, sedangkan iota karaginan akan membentuk gel yang kuat dan stabil bila ada ion kalsium, sehingga dengan penambahan garam KCl hanya kappa karaginan
yang membentuk gel kuat sedangkan pada iota karaginan tetap membentuk gel elastis yang
lemah (Glicksman, 1983). Identifikasi tipe
karaginan ini dilakukan dengan metode yang ada pada US Pharmacopeia (2007).
diperoleh kesetaraan kekerasan media dengan pemadat karaginan hasil ekstraksi sebesar 2,8%.
Bila dilakukan analisis ekonomi dari kedua
jenis agar/pemadat yang dipakai dalam pembuatan media penumbuh bakteri diperoleh
hasil sebagai berikut :

Gambar 4.1 Identifikasi karaginan dengan methylene blue
Kadar agar yang dipakai oleh media komersial adalah 1,5% (b/v). Dengan kadar tersebut, kekerasan media yang dimiliki adalah 25,6 + 1,2 gram atau agar tersebut mulai rusak bila diberi beban sebesar 25,6 + 1,2 gram. Untuk mendapatkan nilai kekerasan yang sama dengan nilai yang dimiliki oleh 1,5% agar pada media komersial, maka dilakukan percobaan dengan mengukur kadar karaginan hasil ekstraksi dengan tingkat kekerasan media yang dihasilkan. Hasilnya ditunjukkan pada gambar 2.

Gambar 2. Pengaruh konsentrasi karaginan
terhadap nilai kekerasan agar (Nilai ± SD, n=30
kali).
Berdasarkan perhitungan dengan menggunakan rumus hasil regresi linier (y = 18,6x – 26,6; dengan nilai korelasi r = 0,973),
-
1. Untuk membuat 1 liter media dengan menggunakan agar komersial diperlukan agar sebanyak 15 gram per liter. Bila harga 1 gram agar ini adalah Rp. 3.219,- (MP Biomedicals, 2010), maka untuk membuat 1 liter media, diperlukan biaya sebesar Rp. 48.285,- untuk komponen agarnya saja.
-
2. Sementara itu untuk membuat 1 liter media dengan karaginan hasil ektraksi diperlukan karaginan sebanyak 28 gram per liter media. Dari penelitian ini, untuk mendapatkan rendemen sebesar 1 gram, diperlukan biaya sebesar Rp. 4.165,-, maka untuk membuat 1 liter media, diperlukan biaya sebesar Rp. 116.620,- untuk komponen agarnya saja.
Uji streak ose digunakan untuk membandingkan persentase kerusakan yang terjadi terhadap tekanan ose yang diberikan. Pada penelitian ini, uji streak hanya dilakukan pada karaginan tipe kappa yang dibandingkan dengan media kontrol. Hasil uji streak ini ditunjukkan pada tabel 1
Tabel 1. Uji streak ose pada media kontrol dan media uji (konsentrasi kappa karaginan 2,8%).
|
Media |
Kerusakan (rata±SD)% | ||
|
Tekanan I |
2,94 ± 0,4 N |
CTR UJI |
0 ± 0,00 0 ± 0,00 |
|
Tekanan II |
6,37 ± 0,3 N |
CTR UJI |
86,67 ± 15,28 90 ± 10,00 |
Keterangan: CTR= media kontrol; Uji= media uji, N= Newton, SD= standar deviasi dari 30 kali pengulangan. Nilai rata-rata menunjukkan hasil yang tidak berbeda nyata (P > 0,05) berdasarkan Independent T-test dengan menggunakan Software Minitab for Windows versi 14.
Pertumbuhan mikroba pada media kontrol dan media uji (konsentrasi kappa karaginan 2,8%) setelah diinkubasi pada 37°C selama 24
jam ditunjukan pada gambar 3 dan tabel 2.
Keterangan : A1 : pertumbuhan E. coli pada media kontrol, A2 : pertumbuhan E. coli pada media uji, B1 : pertumbuhan V. colera pada media kontrol, B2 : pertumbuhan V. colera pada media uji, C1 : pertumbuhan S.aureus pada media kontrol, C2 : pertumbuhan S.aureus pada media uji, D1 : pertumbuhan Rhizopus sp. pada media kontrol, D2 : pertumbuhan Rhizopus sp.pada media uji.
Tabel 2. Rata-rata pertumbuhan mikroba uji setelah diinkubasi pada 37°C selama 24 jam.
|
Kontrol |
Uji | |
|
E. coli (CFU) |
3,08 ± 1,32 (×107) |
3,91 ± 3,54 (×107) |
|
S.aureus |
1,90 ± 1,27 |
2,16 ± 1,60 |
|
(CFU) |
(×107) |
(×107) |
|
V. colera |
2,67 ± 2,73 |
1,98 ± 1,59 |
|
(CFU) |
(×107) |
(×107) |
|
Rhizopus sp. (cm) |
6,88 ± 0,13 |
6,73 ± 0,05 |
|
Keterangan: Nilai pada tabel 2 ± SD, n=9 (P > | ||
|
0,05) | ||
4. PEMBAHASAN
Penggunaan karaginan sebagai pemadat media penumbuh mikroba ternyata lebih mahal jika dibandingkan dengan agar yang dijual secara komersial. Hal ini disebabkan oleh penggunaan isopropilalkohol untuk memurnikan karaginan sehingga menambah biaya ekstraksi lebih besar.
Karaginan dari Eucheuma spinosum (karaginan tipe iota), tidak dapat diuji kekerasannya karena sediaan yang terbentuk mempunyai gel yang lemah. Hal ini disebabkan oleh struktur iota karaginan yang memiliki dua gugus sulfat dimana semakin banyak gugus sulfat, kekuatan gel semakin menurun. Dengan adanya dua gugus sulfat, akan memberikan gaya tolak-menolak antar molekul sehingga sulit terjadi struktur berpilin yang berperan dalam pembentukan gel yang kuat (Moirano, 1977). Dengan keadaan tersebut karaginan tipe iota tidak dapat digunakan sebagai media penumbuh mikroba. Pengujian elastisitas melalui uji ose terlihat pada tabel 1 (P > 0,05). Oleh karena itu, agar yang diekstrak dari Eucheuma cottonii layak dipakai untuk media, walaupun secara ekonomis lebih mahal. Sedangkan untuk kemampuannya dalam menumbuhkan mikroba secara keseluruhan, rata-rata pertumbuhan mikroba pada media kontrol dan media uji dengan (P > 0,05) (Tabel 2), menunjukkan pemadat karaginan layak digunakan.
(kekerasannya) dan kemampuannya dalam menumbuhkan mikroba, walaupun harga per gram hampir 2 kali lebih mahal daripada agar yang dijual secara komersial. Sedangkan
karaginan dari Eucheuma spinosum tidak dapat digunakan sebagai pemadat media karena sediaan yang terbentuk merupakan gel yang lemah.
UCAPAN TERIMAKASIH
Kepada grup riset jurusan farmasi FMIPA
Udayana; seluruh dosen pengajar, serta staf pegawai di Jurusan Farmasi Fakultas MIPA Universitas Udayana atas dukungan yang telah diberikan.
PUSTAKA
Anonim. 2007. United States PharmacopeiaNational Formulary. US: The United States Pharmacopeial Convention.
Anonim a. 2009. Badan Penanaman Modal Provinsi Bali, Rumput Laut. Diunduh dari: http://bpm.baliprov.go.id/index.php?option=c om_content&view=article&id=55:rumput-laut&catid=66:rumput-laut
Anonim b. 2009. Portal Nasional Republik Indonesia; Indonesia Produsen Rumput Laut Terbesar. Diunduh dari :
http://www.indonesia.go.id/id/index.php/files /upload/en/index.php?option=com_content&t ask=view&id=8521&Itemid=696
Aslan, L.M. 1998. Budidaya Rumput Laut. Yogyakarta: Kanisius.
Fulthorpe, A.J. 1951. The Variability in GelProducing Properties of Commercial Agar and Its Influence on Bacterial Growth. The Army Vaccine Laboratory. Vol. 49, No. 2 & 3.
Glicksman, M.1983. Food Hydrocolloids Volume I. Florida: CRC Press Boca Raton.
Syamsuar. 2007. Karakteristik Karaginan Rumput Laut Eucheuma cottonii Pada Berbagai Umur Panen, Konsentrasi KOH dan Lama Ekstraksi. Bogor: Institut Pertanian Bogor.
Rowe, R.C., P.J. Sheskey, and S.C. Owen. 2004.
Pharmaceutical Excipients. US:
Pharmaceutical Press.Vandamme, E., A.
Steinbuchel, S.D. Baets. 2004. Biopolymer, volume 6. Germany : Wiley-VCH
45
Discussion and feedback